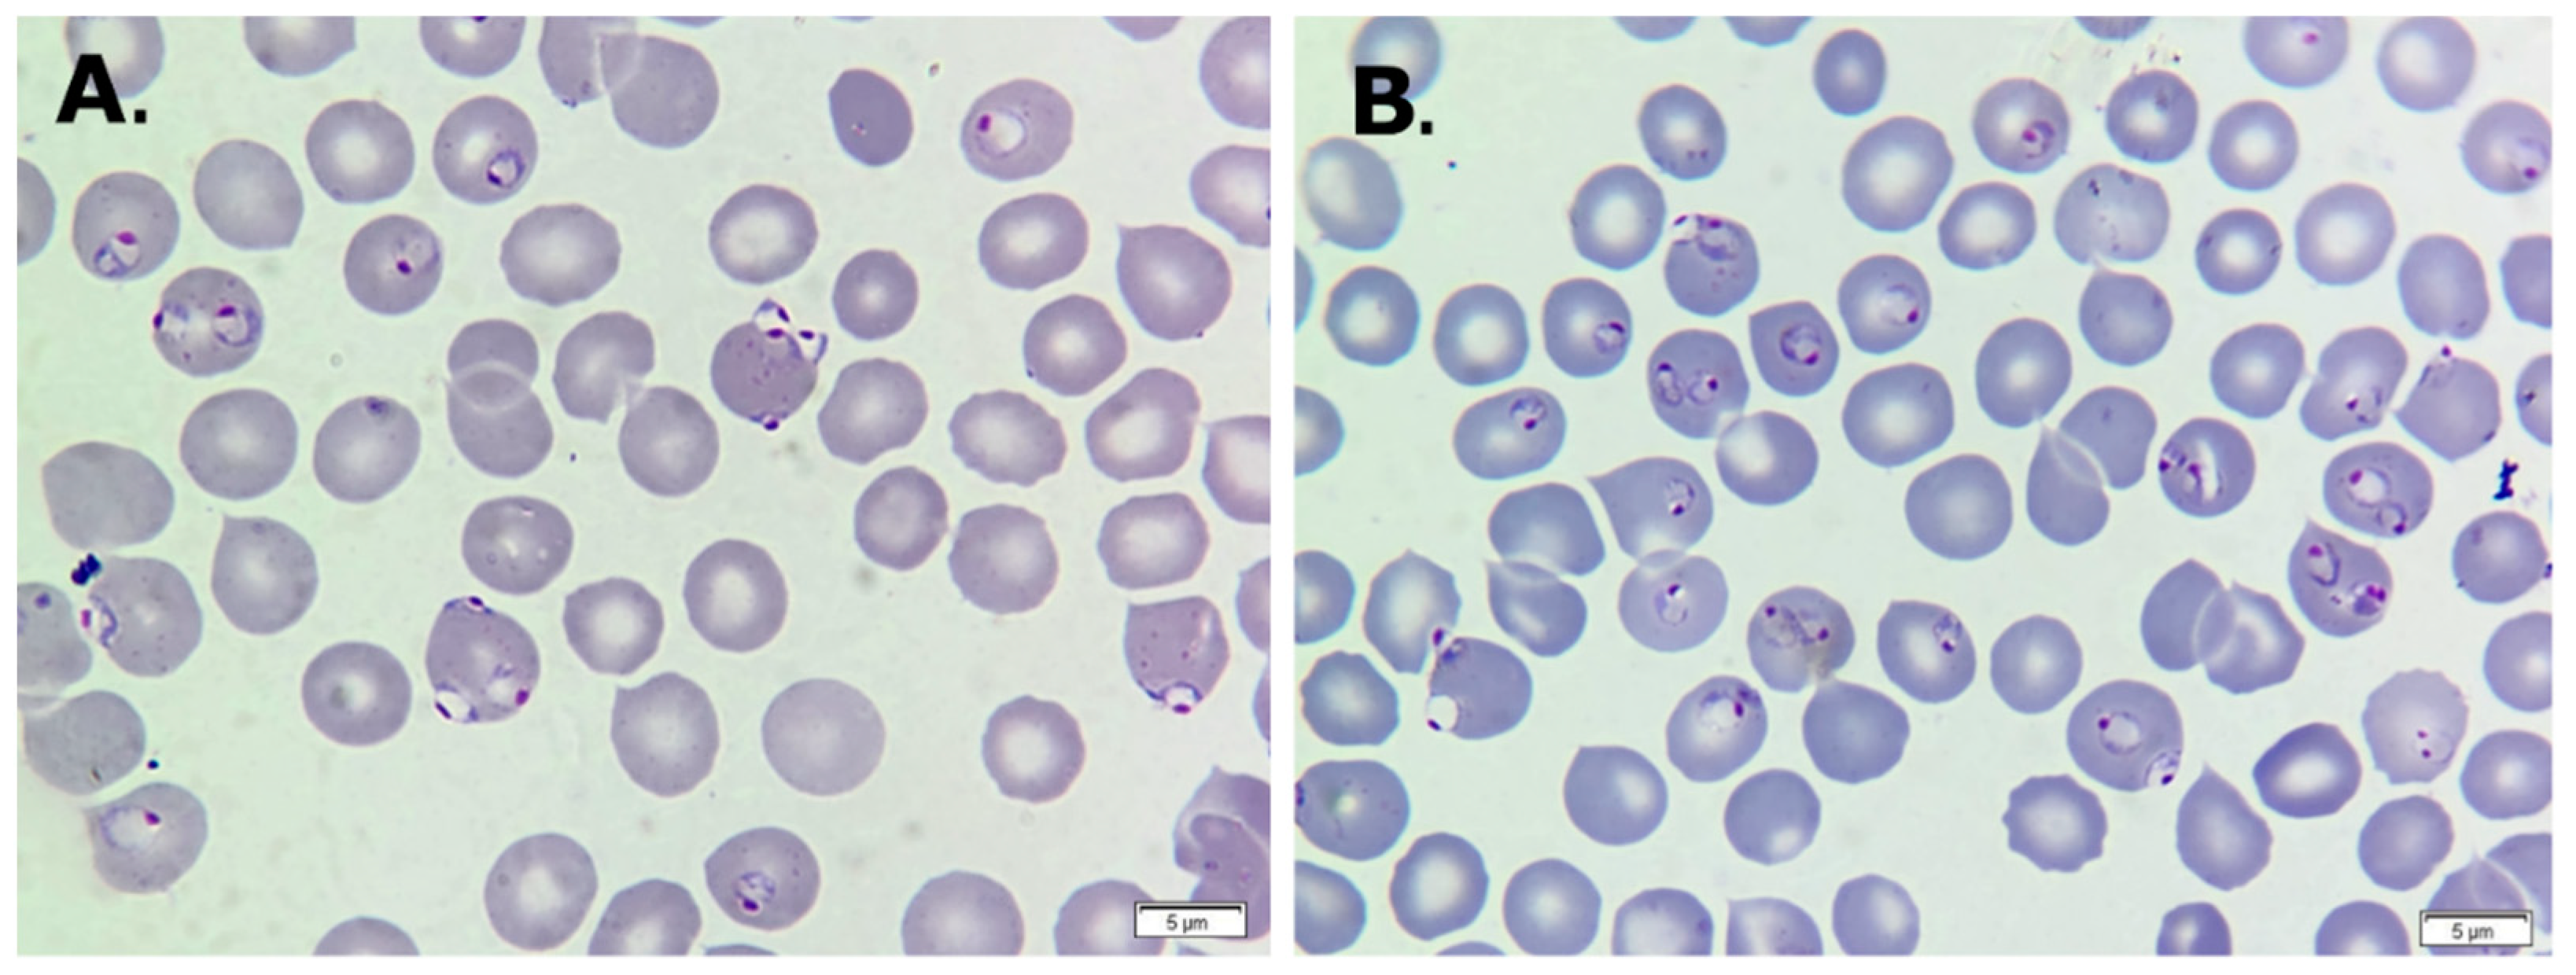
Life 14 01454 g001 Life 14 01454 g001
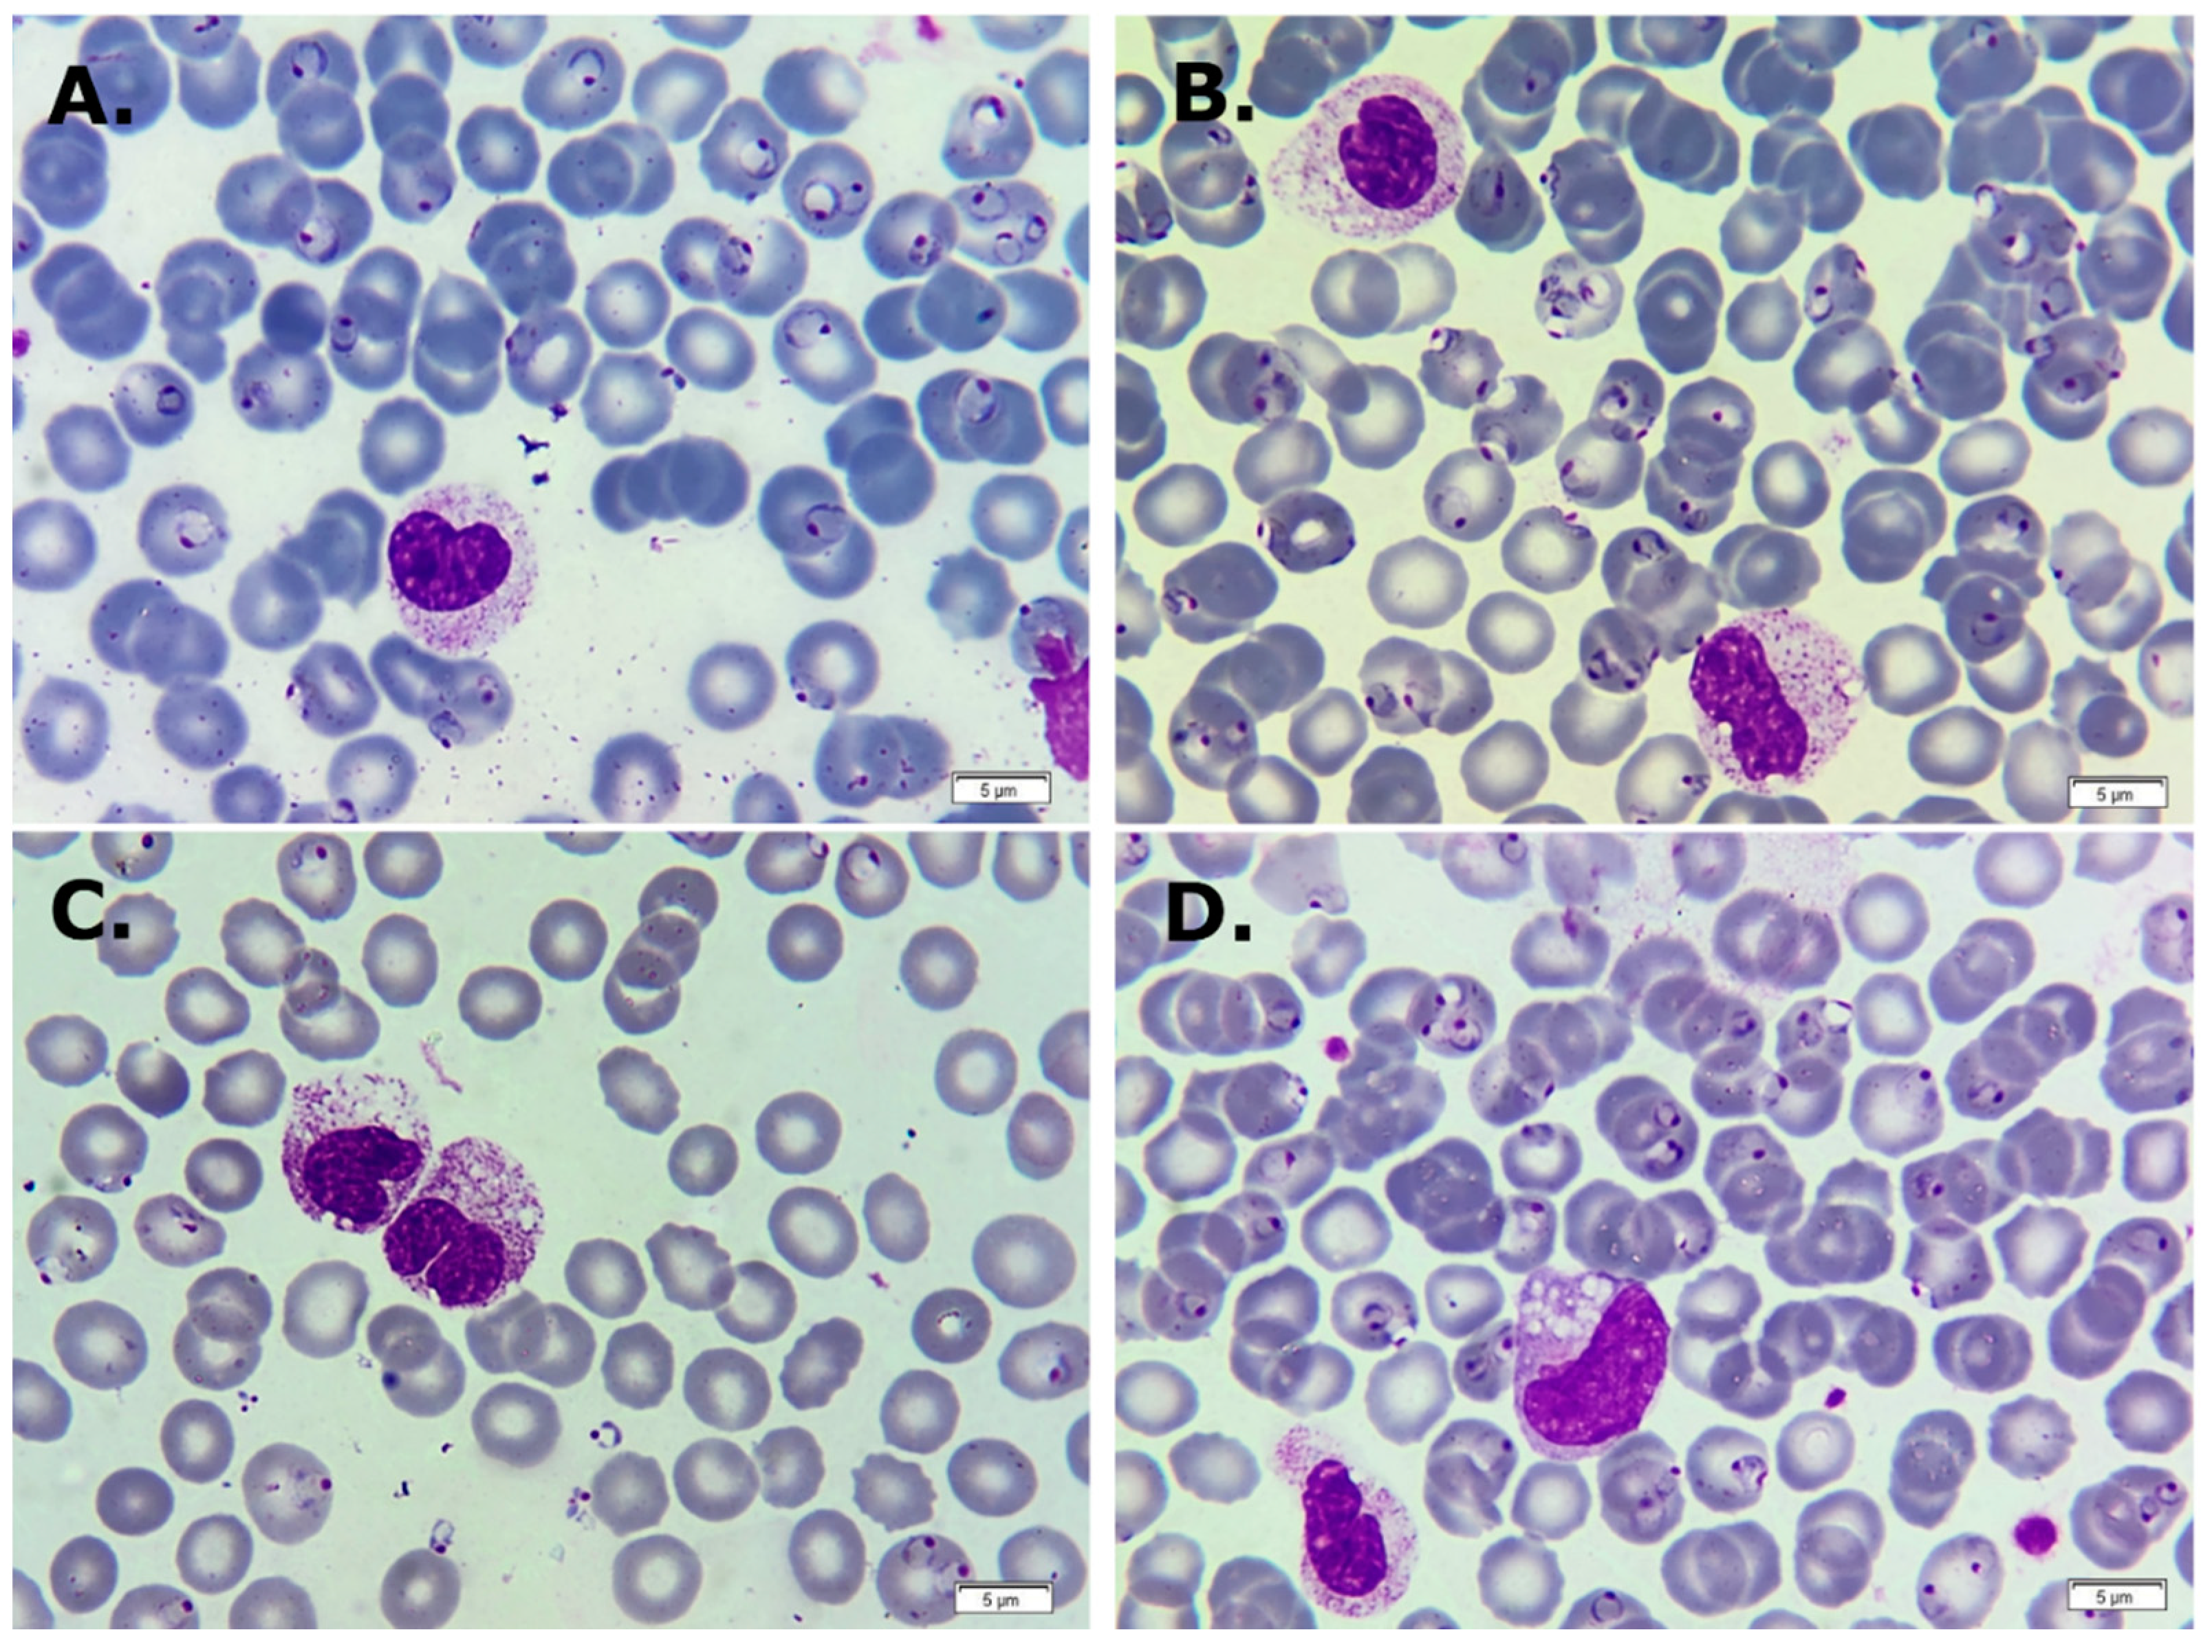
Life 14 01454 g002 Life 14 01454 g002
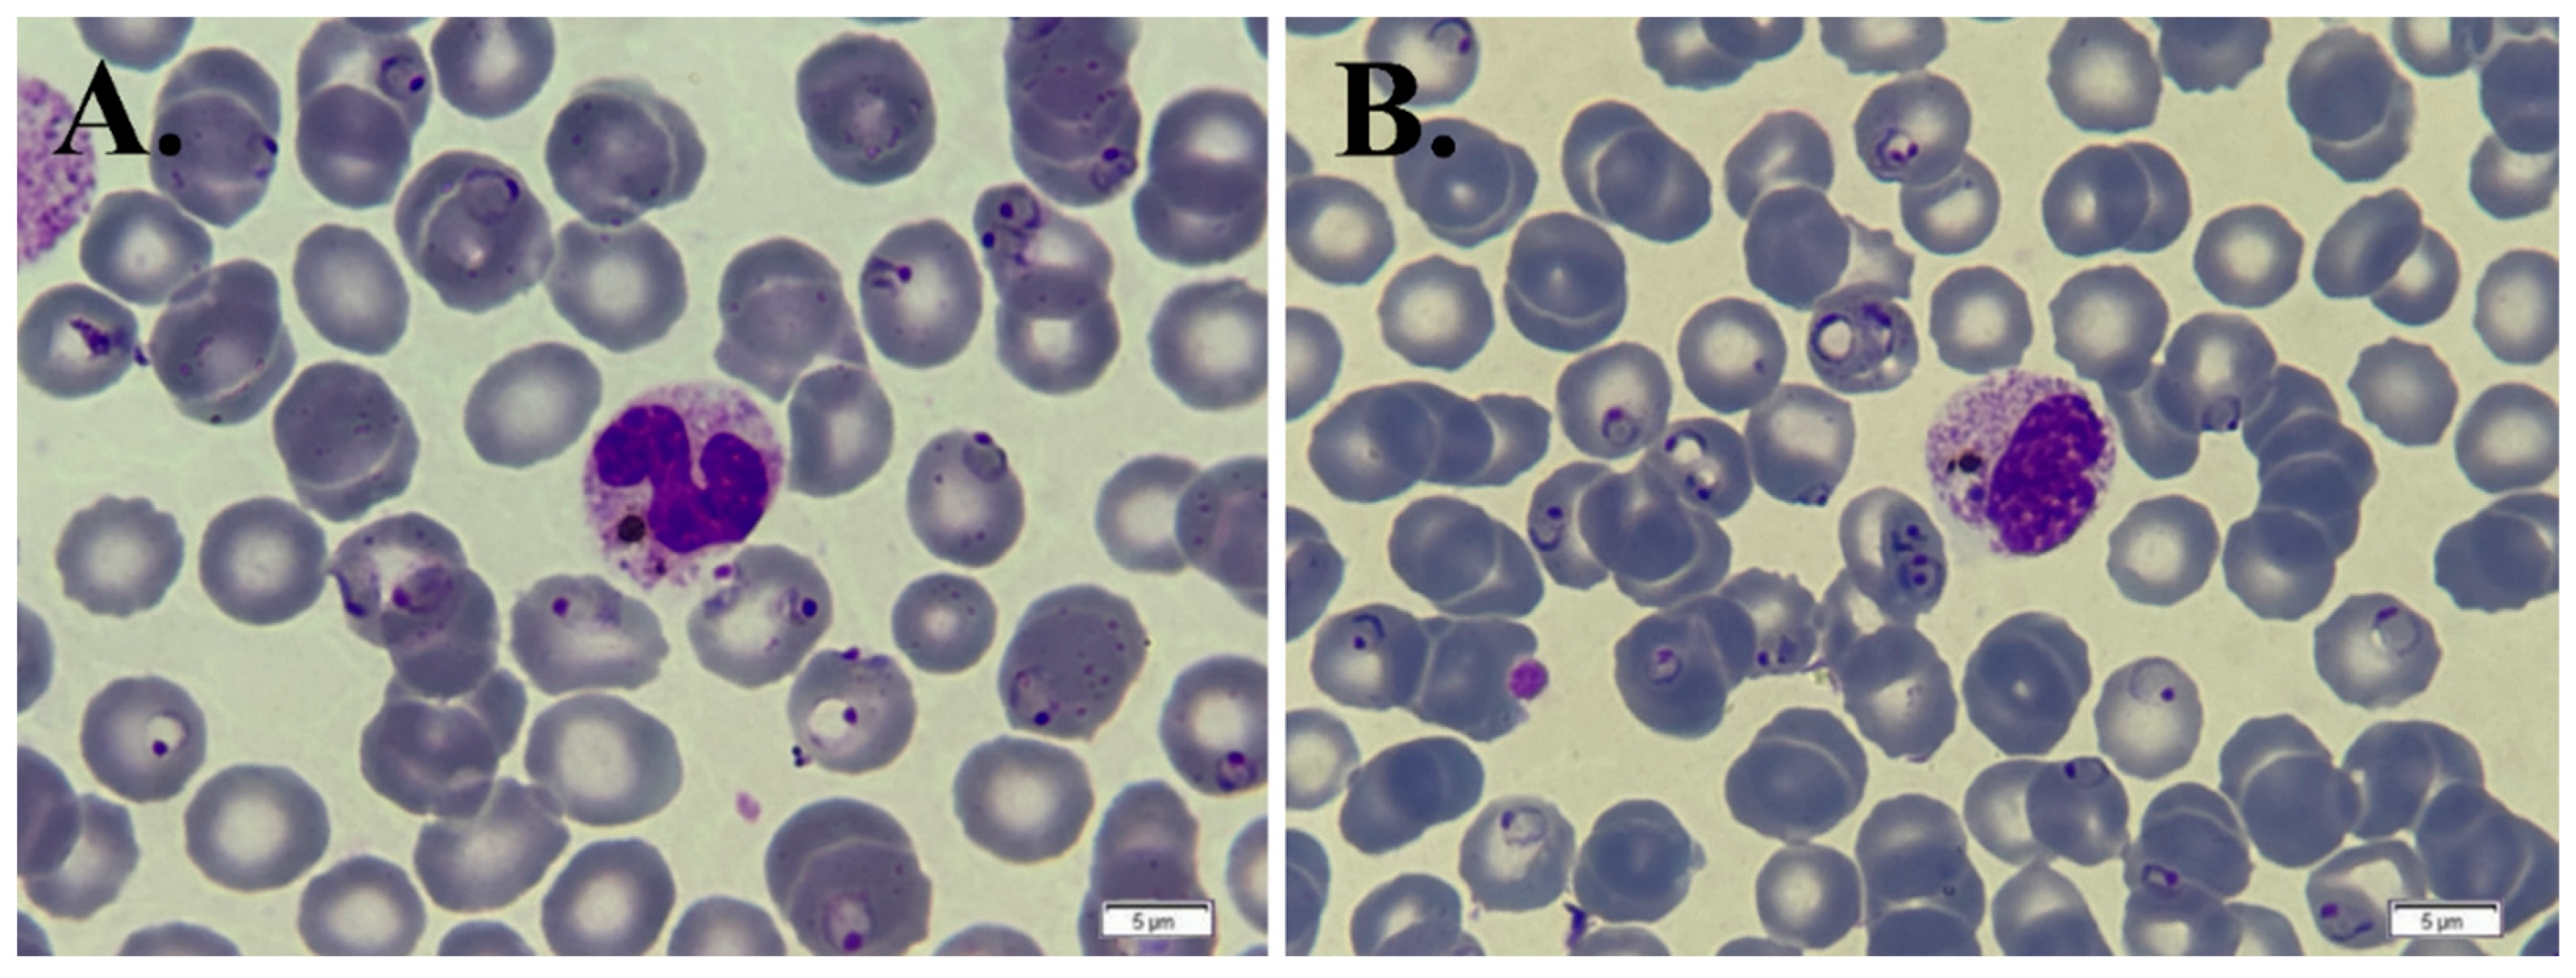
Life 14 01454 g003 Life 14 01454 g003

A Severe Case of Plasmodium falciparum Malaria in a 44-Year-Old Caucasian Woman on Return to Western Romania from a Visit to Nigeria
Abstract
1. Introduction
2. Case Presentation
3. Discussion
4. Conclusions
Author Contributions
Funding
Institutional Review Board Statement
Informed Consent Statement
Data Availability Statement
Conflicts of Interest
References
- World Health Organization. World Malaria Report 2023; World Health Organization: Geneva, Switzerland, 2023; Available online: https://www.who.int/teams/global-malaria-programme/reports/world-malaria-report-2023 (accessed on 28 April 2024).
- Zekar, L.; Sharman, T. Plasmodium Falciparum Malaria. In StatPearls; StatPearls Publishing: Treasure Island, FL, USA, 2024. Available online: https://www.ncbi.nlm.nih.gov/books/NBK555962 (accessed on 28 April 2024).
- Menkin-Smith, L.; Winders, W. Plasmodium Vivax Malaria. In StatPearls; StatPearls Publishing: Treasure Island, FL, USA, 2024. Available online: https://www.ncbi.nlm.nih.gov/books/NBK538333 (accessed on 28 April 2024).
- Malchrzak, W.; Rymer, W.; Inglot, M. Imported Malaria Caused by Plasmodium Falciparum—Case Report. Przegl. Epidemiol. 2018, 72, 363–370. [Google Scholar] [CrossRef] [PubMed]
- Gerstenlauer, C. Recognition and Management of Malaria. Nurs. Clin. N. Am. 2019, 54, 245–260. [Google Scholar] [CrossRef] [PubMed]
- Breman, J.G. Eradicating Malaria. Sci. Prog. 2009, 92, 1–38. [Google Scholar] [CrossRef] [PubMed]
- Beck-Johnson, L.M.; Nelson, W.A.; Paaijmans, K.P.; Read, A.F.; Thomas, M.B.; Bjørnstad, O.N. The Importance of Temperature Fluctuations in Understanding Mosquito Population Dynamics and Malaria Risk. R. Soc. Open Sci. 2017, 4, 160969. [Google Scholar] [CrossRef]
- Buczak, A.L.; Baugher, B.; Guven, E.; Ramac-Thomas, L.C.; Elbert, Y.; Babin, S.M.; Lewis, S.H. Fuzzy Association Rule Mining and Classification for the Prediction of Malaria in South Korea. BMC Med. Inform. Decis. Mak. 2015, 15, 47. [Google Scholar] [CrossRef]
- Ashley, E.A.; Pyae Phyo, A.; Woodrow, C.J. Malaria. Lancet Lond. Engl. 2018, 391, 1608–1621. [Google Scholar] [CrossRef]
- da Silva, G.B.; Pinto, J.R.; Barros, E.J.G.; Farias, G.M.N.; Daher, E.D.F. Kidney Involvement in Malaria: An Update. Rev. Inst. Med. Trop. Sao Paulo 2017, 59, e53. [Google Scholar] [CrossRef]
- Fletcher, T.E.; Beeching, N.J. Malaria. J. R. Army Med. Corps 2013, 159, 158–166. [Google Scholar] [CrossRef]
- Aidoo, M.; Incardona, S. Ten Years of Universal Testing: How the Rapid Diagnostic Test Became a Game Changer for Malaria Case Management and Improved Disease Reporting. Am. J. Trop. Med. Hyg. 2022, 106, 29–32. [Google Scholar] [CrossRef]
- Bain, B.; Bates, I.; Laffan, M.; Lewis, S. Dacie and Lewis Practical Haematology, 12th ed.; Elsevier: Amsterdam, The Netherlands, 2017; pp. 101–107. [Google Scholar]
- Bharti, A.R.; Letendre, S.L.; Patra, K.P.; Vinetz, J.M.; Smith, D.M. Malaria Diagnosis by a Polymerase Chain Reaction–Based Assay Using a Pooling Strategy. Am. J. Trop. Med. Hyg. 2009, 81, 754–757. [Google Scholar] [CrossRef]
- Hermsen, C.C.; Telgt, D.S.; Linders, E.H.; van de Locht, L.A.; Eling, W.M.; Mensink, E.J.; Sauerwein, R.W. Detection of Plasmodium Falciparum Malaria Parasites In Vivo by Real-Time Quantitative PCR. Mol. Biochem. Parasitol. 2001, 118, 247–251. [Google Scholar] [CrossRef] [PubMed]
- Milne, L.M.; Kyi, M.S.; Chiodini, P.L.; Warhurst, D.C. Accuracy of Routine Laboratory Diagnosis of Malaria in the United Kingdom. J. Clin. Pathol. 1994, 47, 740–742. [Google Scholar] [CrossRef] [PubMed]
- Snounou, G.; Viriyakosol, S.; Zhu, X.P.; Jarra, W.; Pinheiro, L.; do Rosario, V.E.; Thaithong, S.; Brown, K.N. High Sensitivity of Detection of Human Malaria Parasites by the Use of Nested Polymerase Chain Reaction. Mol. Biochem. Parasitol. 1993, 61, 315–320. [Google Scholar] [CrossRef] [PubMed]
- Coleman, R.E.; Sattabongkot, J.; Promstaporm, S.; Maneechai, N.; Tippayachai, B.; Kengluecha, A.; Rachapaew, N.; Zollner, G.; Miller, R.S.; Vaughan, J.A.; et al. Comparison of PCR and Microscopy for the Detection of Asymptomatic Malaria in a Plasmodium Falciparum/Vivax Endemic Area in Thailand. Malar. J. 2006, 5, 121. [Google Scholar] [CrossRef]
- Roshanravan, B.; Kari, E.; Gilman, R.H.; Cabrera, L.; Lee, E.; Metcalfe, J.; Calderon, M.; Lescano, A.G.; Montenegro, S.H.; Calampa, C.; et al. Endemic Malaria in the Peruvian Amazon Region of Iquitos. Am. J. Trop. Med. Hyg. 2003, 69, 45–52. [Google Scholar] [CrossRef]
- Kotepui, M.; Kotepui, K.U.; De Jesus Milanez, G.; Masangkay, F.R. Summary of Discordant Results Between Rapid Diagnosis Tests, Microscopy, and Polymerase Chain Reaction for Detecting Plasmodium Mixed Infection: A Systematic Review and Meta-Analysis. Sci. Rep. 2020, 10, 12765. [Google Scholar] [CrossRef]
- Aregawi, S.; Li, L.; Miraglia, C.M. Malaria Rapid Diagnostic Test and Giemsa–Stained Peripheral Blood Smear Discrepancies in the Diagnosis of Plasmodium Ovale Infection in New England. Am. Soc. Clin. Lab. Sci. 2017, 30, 75–83. [Google Scholar] [CrossRef]
- World Health Organization. Management of Severe Malaria: A Practical Handbook, 3rd ed.; World Health Organization: Geneva, Switzerland, 2012; ISBN 978-92-4-154852-6. [Google Scholar]
- Bailey, J.W.; Williams, J.; Bain, B.J.; Parker-Williams, J.; Chiodini, P.L. General Haematology Task Force of the British Committee for Standards in Haematology Guideline: The Laboratory Diagnosis of Malaria. General Haematology Task Force of the British Committee for Standards in Haematology. Br. J. Haematol. 2013, 163, 573–580. [Google Scholar] [CrossRef]
- Akafity, G.; Kumi, N.; Ashong, J. Diagnosis and Management of Malaria in the Intensive Care Unit. J. Intensive Med. 2024, 4, 3–15. [Google Scholar] [CrossRef]
- Daily, J.P.; Minuti, A.; Khan, N. Diagnosis, Treatment, and Prevention of Malaria in the US: A Review. JAMA 2022, 328, 460–471. [Google Scholar] [CrossRef]
- World Health Organization (WHO). Treating Malaria. [Internet]; WHO: Geneva, Switzerland, 2024; Available online: https://www.who.int/teams/global-malaria-programme (accessed on 28 October 2024).
- Shippey, E.A.; Wagler, V.D.; Collamer, A.N. Hydroxychloroquine: An Old Drug with New Relevance. Cleve. Clin. J. Med. 2018, 85, 459–467. [Google Scholar] [CrossRef] [PubMed]
- White, N.J.; Pukrittayakamee, S.; Hien, T.T.; Faiz, M.A.; Mokuolu, O.A.; Dondorp, A.M. Malaria. Lancet Lond. Engl. 2014, 383, 723–735. [Google Scholar] [CrossRef] [PubMed]
- Bloland, P.B.; Ettling, M.; Meek, S. Combination Therapy for Malaria in Africa: Hype or Hope? Bull. World Health Organ. 2000, 78, 1378–1388. [Google Scholar] [PubMed]
- Neghina, R.; Neghina, A.M.; Marincu, I.; Iacobiciu, I. Malaria and the Campaigns toward Its Eradication in Romania, 1923–1963. Vector Borne Zoonotic Dis. Larchmt. N 2011, 11, 103–110. [Google Scholar] [CrossRef]
- Florescu, S.A.; Popescu, C.P.; Calistru, P.; Ceausu, E.; Nica, M.; Toderan, A.; Zaharia, M.; Parola, P. Plasmodium Vivax Malaria in a Romanian Traveller Returning from Greece, August 2011. Euro Surveill. Bull. Eur. Sur Mal. Transm. Eur. Commun. Dis. Bull. 2011, 16, 19954. [Google Scholar] [CrossRef]
- Neghina, R.; Iacobiciu, I.; Neghina, A.M. Malaria in Romania and Its Relationship to International Travel. Infect. Dis. Clin. Pract. 2010, 18, 159–161. [Google Scholar] [CrossRef]
- Neghina, R.; Nicola, E.D.; Nita, C.; Musta, V.; Nicoara, E.; Olariu, T.R. Two Cases of Imported Malaria in Western Romania, 2010–2011. Asian Pac. J. Trop. Med. 2012, 5, 326–328. [Google Scholar] [CrossRef]
- Florescu, S.A.; Larsen, C.S.; Helleberg, M.; Marin, A.; Popescu, C.P.; Schlagenhauf, P. Upsurge in Cases of Travellers’ Malaria Ex Zanzibar Indicates That Malaria Is on the Rebound in the Archipelago. New Microbes New Infect. 2024, 57, 101226. [Google Scholar] [CrossRef]
- Centers for Disease Control and Prevention. Blood Specimen Diagnostic Procedures. Available online: https://www.cdc.gov/dpdx/diagnosticprocedures/blood/microexam.html (accessed on 29 September 2024).
- Centers for Disease Control and Prevention. Malaria Diagnostic Tests. Available online: https://www.cdc.gov/malaria/hcp/diagnosis-testing/malaria-diagnostic-tests.html (accessed on 29 September 2024).
- Matsee, W.; Chatapat, L.; Chotivanich, K.; Piyaphanee, W. Case Report: A Cluster of Plasmodium Falciparum Malaria Cases among Thai Workers in Gembu, Nigeria. Am. J. Trop. Med. Hyg. 2018, 99, 623–626. [Google Scholar] [CrossRef]
- World Health Organization. Malaria. 2023. Available online: https://www.who.int/news-room/fact-sheets/detail/malaria (accessed on 29 September 2024).
- Crutcher, J.; Hoffman, S. Malaria. In Medical Microbiology; Baron, S., Ed.; University of Texas Medical Branch at Galveston: Galveston, TX, USA, 1996. [Google Scholar]
- Facer, C. Hematological Aspects of Malaria. In Infection and Hematology; Butterworth Heinmann Ltd.: Oxford, UK, 1994; pp. 259–294. [Google Scholar]
- Richards, M.W.; Behrens, R.H.; Doherty, J.F. Short Report: Hematologic Changes in Acute, Imported Plasmodium Falciparum Malaria. Am. J. Trop. Med. Hyg. 1998, 59, 859. [Google Scholar] [CrossRef][Green Version]
- Svenson, J.E.; MacLean, J.D.; Gyorkos, T.W.; Keystone, J. Imported Malaria. Clinical Presentation and Examination of Symptomatic Travelers. Arch. Intern. Med. 1995, 155, 861–868. [Google Scholar] [CrossRef] [PubMed]
- Dasgupta, A.; Rai, S.; Das Gupta, A. Persistently Elevated Laboratory Markers of Thrombosis and Fibrinolysis after Clinical Recovery in Malaria Points to Residual and Smouldering Cellular Damage. Indian J. Hematol. Blood Transfus. 2012, 28, 29–36. [Google Scholar] [CrossRef] [PubMed][Green Version]
- Naik, B.S. Incidence of Jaundice in Plasmodium Vivax Malaria: A Prospective Study in Moodabidri, South India. Malays. J. Med. Sci. MJMS 2014, 21, 24–27. [Google Scholar] [PubMed]
- Kochar, D.K.; Das, A.; Kochar, S.K.; Saxena, V.; Sirohi, P.; Garg, S.; Kochar, A.; Khatri, M.P.; Gupta, V. Severe Plasmodium Vivax Malaria: A Report on Serial Cases from Bikaner in Northwestern India. Am. J. Trop. Med. Hyg. 2009, 80, 194–198. [Google Scholar] [CrossRef]
- Kouam, A.F.; Ngoumé, N.A.N.; Fepa, A.G.K.; Wainfen, Z.; Ngounou, E.; Galani, B.R.T.; Nembo, N.E.; Chuisseu, P.D.D.; Njayou, F.N.; Moundipa, P.F. Liver Injury in Malaria Infected Patients in Douala-Cameroon and Its Association with Poor Medical Practice. Egypt. Liver J. 2023, 13, 67. [Google Scholar] [CrossRef]
- Megabiaw, F.; Eshetu, T.; Kassahun, Z.; Aemero, M. Liver Enzymes and Lipid Profile of Malaria Patients Before and After Antimalarial Drug Treatment at Dembia Primary Hospital and Teda Health Center, Northwest, Ethiopia. Res. Rep. Trop. Med. 2022, 13, 11–23. [Google Scholar] [CrossRef]
- Pinto, M.P.B. Malaria, the Role of the Blood Smear—A Case Report. Hematol. Transfus. Cell Ther. 2019, 41, 185–186. [Google Scholar] [CrossRef]
- Chang, C.Y. Clinical Characteristics and Outcome of Severe Malaria in Kapit, Sarawak, Malaysian Borneo. J. Vector Borne Dis. 2023, 60, 432–434. [Google Scholar] [CrossRef]
- Lima-Junior, J.d.C.; Rodrigues-da-Silva, R.N.; Pereira, V.A.; Storer, F.L.; Perce-da-Silva, D.d.S.; Fabrino, D.L.; Santos, F.; Banic, D.M.; de Oliveira-Ferreira, J. Cells and Mediators of Inflammation (C-Reactive Protein, Nitric Oxide, Platelets and Neutrophils) in the Acute and Convalescent Phases of Uncomplicated Plasmodium Vivax and Plasmodium Falciparum Infection. Mem. Inst. Oswaldo Cruz 2012, 107, 1035–1041. [Google Scholar] [CrossRef]
- Rocha, B.C.; Marques, P.E.; Leoratti, F.M.d.S.; Junqueira, C.; Pereira, D.B.; Antonelli, L.R.d.V.; Menezes, G.B.; Golenbock, D.T.; Gazzinelli, R.T. Type I Interferon Transcriptional Signature in Neutrophils and Low-Density Granulocytes Are Associated with Tissue Damage in Malaria. Cell Rep. 2015, 13, 2829–2841. [Google Scholar] [CrossRef]
- Pollenus, E.; Gouwy, M.; Van den Steen, P.E. Neutrophils in Malaria: The Good, the Bad or the Ugly? Parasite Immunol. 2022, 44, e12912. [Google Scholar] [CrossRef] [PubMed]
- Olivier, M.; Van Den Ham, K.; Shio, M.T.; Kassa, F.A.; Fougeray, S. Malarial Pigment Hemozoin and the Innate Inflammatory Response. Front. Immunol. 2014, 5, 25. [Google Scholar] [CrossRef]
- Coronado, L.M.; Nadovich, C.T.; Spadafora, C. Malarial Hemozoin: From Target to Tool. Biochim. Biophys. Acta 2014, 1840, 2032–2041. [Google Scholar] [CrossRef] [PubMed]
- Bain, B.J. Malaria Pigment. Am. J. Hematol. 2011, 86, 302. [Google Scholar] [CrossRef]
- Sandalinas, F.; Filteau, S.; Joy, E.J.M.; Segovia de la Revilla, L.; MacDougall, A.; Hopkins, H. Measuring the Impact of Malaria Infection on Indicators of Iron and Vitamin A Status: A Systematic Literature Review and Meta-Analysis. Br. J. Nutr. 2023, 129, 87–103. [Google Scholar] [CrossRef]
- Wilairatana, P.; Mahannop, P.; Tussato, T.; Hayeedoloh, I.-M.; Boonhok, R.; Klangbud, W.K.; Mala, W.; Kotepui, K.U.; Kotepui, M. C-Reactive Protein as an Early Biomarker for Malaria Infection and Monitoring of Malaria Severity: A Meta-Analysis. Sci. Rep. 2021, 11, 22033. [Google Scholar] [CrossRef]
- Hurt, N.; Smith, T.; Tanner, M.; Mwankusye, S.; Bordmann, G.; Weiss, N.A.; Teuscher, T. Evaluation of C-Reactive Protein and Haptoglobin as Malaria Episode Markers in an Area of High Transmission in Africa. Trans. R. Soc. Trop. Med. Hyg. 1994, 88, 182–186. [Google Scholar] [CrossRef] [PubMed]
- Paul, R.; Sinha, P.K.; Bhattacharya, R.; Banerjee, A.K.; Raychaudhuri, P.; Mondal, J. Study of C Reactive Protein as a Prognostic Marker in Malaria from Eastern India. Adv. Biomed. Res. 2012, 1, 41. [Google Scholar] [CrossRef] [PubMed]
- Delaigue, S.; Signolet, I.; Consigny, P.H.; de Gentile, L.; D’Ortenzio, E.; Gautret, P.; Sorge, F.; Strady, C.; Bouchaud, O. New Guidelines for the Prevention of Imported Malaria in France. Med. Mal. Infect. 2020, 50, 113–126. [Google Scholar] [CrossRef]
- Sturrock, H.J.W.; Roberts, K.W.; Wegbreit, J.; Ohrt, C.; Gosling, R.D. Tackling Imported Malaria: An Elimination Endgame. Am. J. Trop. Med. Hyg. 2015, 93, 139–144. [Google Scholar] [CrossRef]
- Kolifarhood, G.; Raeisi, A.; Ranjbar, M.; Haghdoust, A.A.; Schapira, A.; Hashemi, S.; Masoumi-Asl, H.; Mozafar Saadati, H.; Azimi, S.; Khosravi, N.; et al. Prophylactic Efficacy of Primaquine for Preventing Plasmodium Falciparum and Plasmodium Vivax Parasitaemia in Travelers: A Meta-Analysis and Systematic Review. Travel Med. Infect. Dis. 2017, 17, 5–18. [Google Scholar] [CrossRef] [PubMed]
- Centers for Disease Control and Prevention (CDC). Malaria: Diagnosis & Treatment. [Internet]; CDC: Atlanta, GA, USA, 2024. Available online: https://www.cdc.gov/malaria/php/public-health-strategy/case-diagnosis-treatment.html (accessed on 28 October 2024).
- Mousa, A.; Al-Taiar, A.; Anstey, N.M.; Badaut, C.; Barber, B.E.; Bassat, Q.; Challenger, J.D.; Cunnington, A.J.; Datta, D.; Drakeley, C.; et al. The Impact of Delayed Treatment of Uncomplicated P. Falciparum Malaria on Progression to Severe Malaria: A Systematic Review and a Pooled Multicentre Individual-Patient Meta-Analysis. PLoS Med. 2020, 17, e1003359. [Google Scholar] [CrossRef] [PubMed]
- Oboh, M.A.; Ndiaye, D.; Antony, H.A.; Badiane, A.S.; Singh, U.S.; Ali, N.A.; Bharti, P.K.; Das, A. Status of Artemisinin Resistance in Malaria Parasite Plasmodium Falciparum from Molecular Analyses of the Kelch13 Gene in Southwestern Nigeria. BioMed Res. Int. 2018, 2018, 2305062. [Google Scholar] [CrossRef] [PubMed]
- Falade, C.O.; Ogundele, A.O.; Yusuf, B.O.; Ademowo, O.G.; Ladipo, S.M. High Efficacy of Two Artemisinin-Based Combinations (Artemether-Lumefantrine and Artesunate plus Amodiaquine) for Acute Uncomplicated Malaria in Ibadan, Nigeria. Trop. Med. Int. Health 2008, 13, 635–643. [Google Scholar] [CrossRef]
- Ajogbasile, F.V.; Oluniyi, P.E.; Kayode, A.T.; Akano, K.O.; Adegboyega, B.B.; Philip, C.; Ogbulafor, N.; Okafor, H.U.; Oguche, S.; Wammanda, R.D.; et al. Molecular Profiling of the Artemisinin Resistance Kelch 13 Gene in Plasmodium Falciparum from Nigeria. PLoS ONE 2022, 17, e0264548. [Google Scholar] [CrossRef]
- Zhao, D.; Zhang, H.; Ji, P.; Li, S.; Yang, C.; Liu, Y.; Qian, D.; Deng, Y.; Wang, H.; Lu, D.; et al. Surveillance of Antimalarial Drug-Resistance Genes in Imported Plasmodium Falciparum Isolates from Nigeria in Henan, China, 2012–2019. Front. Cell. Infect. Microbiol. 2021, 11, 644576. [Google Scholar] [CrossRef]
- Nakayama, K.; Shimizu, T. Reducing the Delay in Initiation of Treatment Improved Clinical Outcomes in Patients with Imported Malaria. Jpn. J. Infect. Dis. 2014, 67, 27–32. [Google Scholar] [CrossRef]
- Landier, J.; Parker, D.M.; Thu, A.M.; Carrara, V.I.; Lwin, K.M.; Bonnington, C.A.; Pukrittayakamee, S.; Delmas, G.; Nosten, F.H. The Role of Early Detection and Treatment in Malaria Elimination. Malar. J. 2016, 15, 363. [Google Scholar] [CrossRef]
- Lüthi, B.; Schlagenhauf, P. Risk Factors Associated with Malaria Deaths in Travellers: A Literature Review. Travel Med. Infect. Dis. 2015, 13, 48–60. [Google Scholar] [CrossRef]

| Laboratory Test | Normal Range | Day 1 | Day 2 |
|---|---|---|---|
| White Cell Count (WBC) | 4000–11,000/µL | 4020/µL | 5620/µL |
| Neutrophils | 40–60% | 87.90% | 72.40% |
| Lymphocytes | 20–40% | 8.20% | 4.07% |
| Eosinophils | 1–4% | 1.50% | 0.50% |
| Platelets | 150,000–450,000/µL | 8000/µL | 16,000/µL |
| Hemoglobin | 12.0–15.5 g/dL | 14.70 g/dL | 13.30 g/dL |
| Hematocrit | 34.9–44.5% | 42.70% | 37.40% |
| Mean Corpuscular Volume (MCV) | 80–100 fL | 89.2 fL | 89 fL |
| Blood Glucose | 70–110 mg/dL | 108.72 mg/dL | - |
| Blood Urea Nitrogen (BUN) | 7–20 mg/dL | 59.80 mg/dL | - |
| Creatinine | 0.6–1.3 mg/dL | 1.67 mg/dL | - |
| Estimated Glomerular Filtration Rate (eGFR) | >60 mL/min/1.73 m2 | 36.95 mL/min/1.73 m2 | - |
| Alanine Transaminase (ALT) | 7–56 U/L | 179.3 U/L | - |
| Aspartate Transaminase (AST) | 10–40 U/L | 172.3 U/L | - |
| D-dimer | <0.5 µg/mL FEU | >5.00 µg/mL FEU | 48.10 µg/mL FEU |
| Presepsin | 60–400 pg/mL | 3960 pg/mL | - |
| Amylase | 23–85 U/L | 18.2 U/L | - |
| Sodium | 135–145 mmol/L | - | 136 mmol/L |
| Potassium | 3.5–5.1 mmol/L | - | 3.53 mmol/L |
| Chloride | 98–107 mmol/L | - | 104 mmol/L |
| Lactate Dehydrogenase (LDH) | 140–280 U/L | - | 464 U/L |
| Total Bilirubin | 0.1–1.2 mg/dL | - | 6.22 mg/dL |
| Direct Bilirubin | 0–0.3 mg/dL | - | 5.58 mg/dL |
| Gamma-glutamyl Transferase (GGT) | 9–48 U/L | - | 107 U/L |
| Alkaline Phosphatase (ALP) | 44–147 U/L | - | 111 U/L |
| Interleukin-6 (IL-6) | <7 pg/mL | - | 57.45 pg/mL |
| Procalcitonin | <0.05 ng/mL | - | 6.04 ng/mL |
| Thrombin Time | 12–14 s | - | 66 s |
| Activated Partial Thromboplastin Time (APTT) | 21–35 s | - | 36.20 s |
| Ferritin | 13–150 ng/mL | - | >2000 ng/mL |
| Total Protein | 6.0–8.3 g/dL | - | 5.73 g/dL |
| C-reactive Protein (CRP) | <10 mg/L | - | 201.18 mg/L |
| Medication | Dose |
|---|---|
| Fitomenadion | 1 vial of 10 mg/mL |
| Etamsylate | 1 vial of 250 mg/2 mL |
| Adrenostazin | 1 vial of 0.3 mg/mL |
| Amoxiplus | 2 vials of 1000 mg/200 mg |
| Aspatofort | 2 vials of 10 mL |
| Arginine–Sorbitol | 1 vial of 250 mL (50 mg/mL + 100 mg/mL) |
| Pantoprazole SUN | 1 vial of 40 mg |
| Sodium Chloride 0.9% | 2 vials × 500 mL |
| Glucose 5% | 1 vial × 500 mL |
| Platelet Mass | 4 units |
| Fresh Frozen Plasma (FFP) | 1 unit |
Disclaimer/Publisher’s Note: The statements, opinions and data contained in all publications are solely those of the individual author(s) and contributor(s) and not of MDPI and/or the editor(s). MDPI and/or the editor(s) disclaim responsibility for any injury to people or property resulting from any ideas, methods, instructions or products referred to in the content. |
© 2024 by the authors. Licensee MDPI, Basel, Switzerland. This article is an open access article distributed under the terms and conditions of the Creative Commons Attribution (CC BY) license (https://creativecommons.org/licenses/by/4.0/).
Share and Cite
Mihu, A.G.; Lighezan, R.; Oatis, D.A.; Mederle, O.A.; Petrine-Mocanu, C.; Petrescu, C.; Prisca, M.E.; Ghenciu, L.A.; Avram, C.R.; Lupu, M.A.; et al. A Severe Case of Plasmodium falciparum Malaria in a 44-Year-Old Caucasian Woman on Return to Western Romania from a Visit to Nigeria. Life 2024, 14, 1454. https://doi.org/10.3390/life14111454
Mihu AG, Lighezan R, Oatis DA, Mederle OA, Petrine-Mocanu C, Petrescu C, Prisca ME, Ghenciu LA, Avram CR, Lupu MA, et al. A Severe Case of Plasmodium falciparum Malaria in a 44-Year-Old Caucasian Woman on Return to Western Romania from a Visit to Nigeria. Life. 2024; 14(11):1454. https://doi.org/10.3390/life14111454
Chicago/Turabian StyleMihu, Alin Gabriel, Rodica Lighezan, Daniela Adriana Oatis, Ovidiu Alexandru Mederle, Cristina Petrine-Mocanu, Cristina Petrescu, Mirandolina Eugenia Prisca, Laura Andreea Ghenciu, Cecilia Roberta Avram, Maria Alina Lupu, and et al. 2024. "A Severe Case of Plasmodium falciparum Malaria in a 44-Year-Old Caucasian Woman on Return to Western Romania from a Visit to Nigeria" Life 14, no. 11: 1454. https://doi.org/10.3390/life14111454
APA StyleMihu, A. G., Lighezan, R., Oatis, D. A., Mederle, O. A., Petrine-Mocanu, C., Petrescu, C., Prisca, M. E., Ghenciu, L. A., Avram, C. R., Lupu, M. A., Bica, A., & Olariu, T. R. (2024). A Severe Case of Plasmodium falciparum Malaria in a 44-Year-Old Caucasian Woman on Return to Western Romania from a Visit to Nigeria. Life, 14(11), 1454. https://doi.org/10.3390/life14111454









